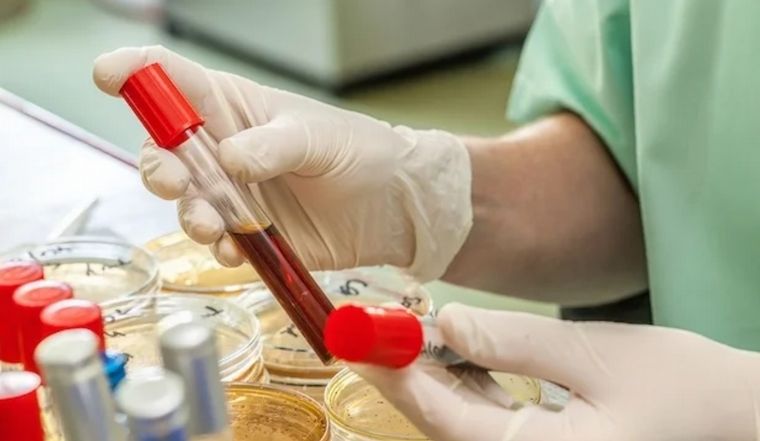

Qué es la hipercalcemia, la enfermedad que afectó a Claudia Pirán
Se trata de una enfermedad en la que el nivel de calcio en sangre está por encima del normal. Como consecuencia debilita huesos, forma cálculos renales e interfiere en el funcionamiento del corazón.
09/11/2023 | 12:06Redacción Cadena 3
La cantante sanjuanina Claudia Pirán murió este miércoles a la noche, a los 51 años, tras permanecer internada desde el sábado pasado en el Hospital Rawson de su provincia, aquejada por una grave enfermedad.
Según se conoció tenía hipercalcemia, una enfermedad en la que el nivel de calcio en la sangre está por encima del normal.
Según explica Mayo Clinic demasiado calcio en la sangre puede debilitar los huesos, formar cálculos renales e interferir en el funcionamiento del corazón y el cerebro.
/Inicio Código Embebido/
Mirá también
/Fin Código Embebido/
La hipercalcemia puede ser el resultado de la hiperactividad de las glándulas paratiroides, el cáncer, trastornos médicos específicos y el uso excesivo de suplementos de calcio y vitamina D.
La hipercalcemia puede no tener signos ni síntomas, o estos pueden ser graves. El tratamiento depende de la causa.
Mayo Clinic explica que "en la mayoría de los casos, el exceso de calcio en la sangre proviene de los huesos, lo cual los debilita causando dolor en los huesos y debilidad muscular".
Además, en raras ocasiones cuando ya es grave puede interferir en la función cardíaca, lo cual causa palpitaciones y desmayos, indicaciones de arritmia cardíaca y otros problemas cardíacos.
La enfermedad puede ser generada por varios factores, pero muchas veces las personas que tiene una enfermedad que las obliga a permanecer sentadas o acostadas durante mucho tiempo pueden desarrollar hipercalcemia con el paso del tiempo.
El diagnóstico puede también presentar complicaciones como osteoporosis, cálculos renales, insuficiencia renal, problemas en el sistema nervioso, ritmo cardíaco anormal.